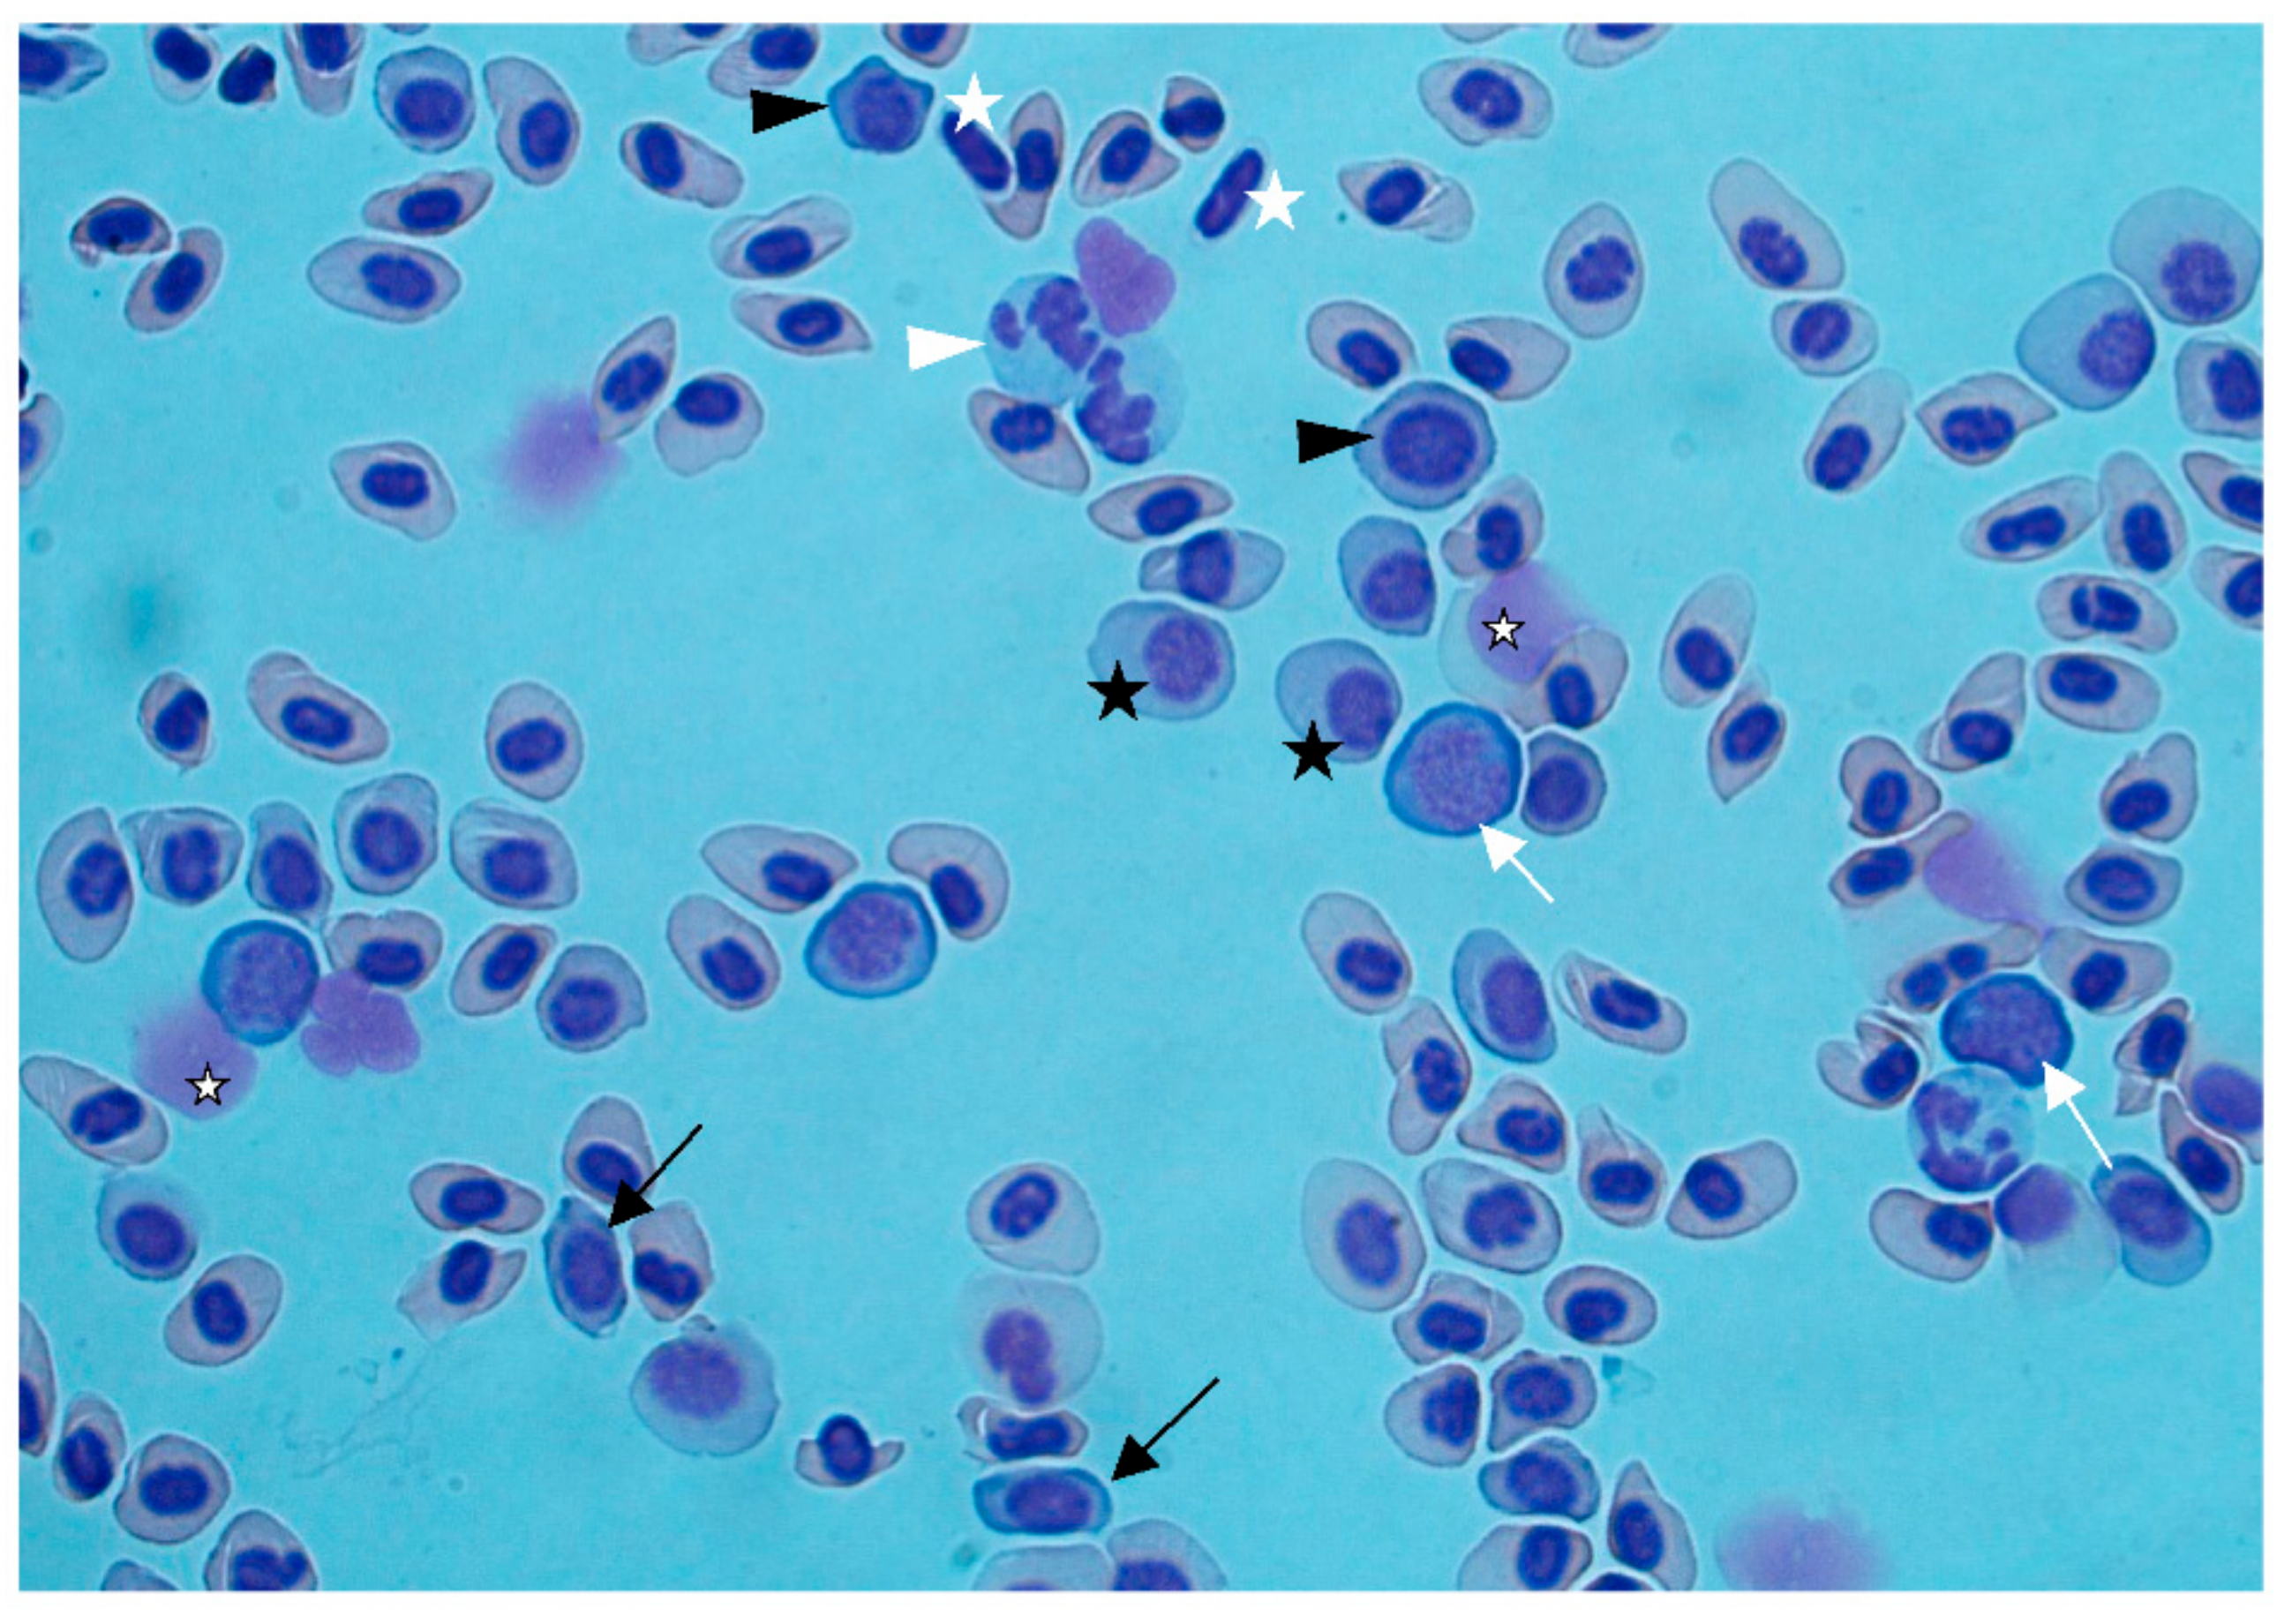
Fishes 03 00042 g003

1. Introduction
Sturgeon farming increased in the last decade due to the demand for caviar and sturgeon meat [
1,
2]. Sturgeons adapted well to farming conditions, but due to limited knowledge about epidemiology and disease control methods, infectious disease is a major challenge in sturgeon aquaculture [
1]. In addition, none of the primary viral infections (nervous necrosis virus (NNV), Acipenser iridoviruses, Acipenser herpesviruses, and Acipenser adenovirus) that can cause extensive losses in sturgeon farms are regulated in the World Organization for Animal Health (OIE) or European Union (EU) legislations. This means that regular screening for viral disease and restrictions for trade are poorly implemented, contributing to the spread of pathogens through subclinically infected individuals.
In recent years, several mortality events in different sturgeon farms across Europe were investigated [
1,
3]. The same etiological agent, a new virus, was detected and associated with clinical disease in different sturgeon species (
Acipenser baerii,
A. gueldenstaedtii,
A. naccari, and
Huso huso). The virus—Acipenser iridovirus European (AcIV-E)—appeared to be closely related to North American sturgeon iridoviruses, in particular with the white sturgeon iridovirus (WSIV) and the Namao virus (NV). The taxonomical classification of these viruses is yet to be elucidated. They were recently moved from
Iridoviridae to
Mimiviridae [
4,
5], a viral family characterized by extreme genomic complexity and plasticity. In fact, the genomes of these viruses are still largely unknown. Additionally, much other important information, e.g., pathogenesis, transmission routes, and epidemiology of these viruses, is lacking, making virus and disease control extremely difficult. Unfortunately, all virus isolation attempts failed, hindering the comprehension of many of these aspects.
In the summer of 2017, a newly built recirculating aquaculture system (RAS) farm in Sweden received a batch of 2000 Siberian sturgeon (Acipenser baerii) juveniles from an Italian farm. Due to disease and mortalities that occurred, a diagnostic investigation was performed.
2. Results
2.1. Case History
The Swedish farm ordered 7 g juveniles; however, on arrival, the average weight was 3.5 g. The age of the juveniles was not stated; however, according to a growth curve, it takes approximately 45 days for Siberian sturgeon juveniles to reach 3.5–4 g (Swedish farmer, personal communication). These were the first fish introduced to the farm; thus, no disease could have been present at the site prior to this import. The juveniles were transported in aerated plastic bags inside a box. The box was not sent with live animal markings, and it is unclear whether it was placed in a pressurized cabin or not during the flight. In addition, customs clearance in Sweden was delayed for several hours because the package was not sent to the animal border control station. By the time the fish reached the farm, they were in transit for 12–14 h. All juveniles were put together in a 20 m3 tank, producing a fish density of 350 g/m3. Water temperature was approximately 20 °C. Additional tanks without fish were run in parallel to start up the facility. The water was mainly recirculated; however, approximately 15 m3 of municipal water that settled in sedimentation tanks for 36–48 h before being transferred to the fish tanks was added each day. Water quality (oxygen, carbon dioxide, nitrate, nitrite, ammonium, pH, and sodium chloride) was continuously monitored. During transport and in the next few days, 30% of the juveniles died. The remaining 70% of the batch seemed to settle properly; however, about 10 days after arrival, the juveniles started displaying buoyancy problems, lethargy, and anorexia, and mortalities started to occur again. The day before that, the farmer altered the water inlet by mixing well water into the municipal water. No surge in dissolved nitrogen, oxygen, or other water parameters were recorded; however, the farmer suspected gas bubble disease and returned to a full municipal water supply. Still, disease and mortalities continued. After another week, a diagnostic investigation was started to look deeper into the problem and rule out infectious disease.
2.2. Clinical Observation and Necropsy
In the first batch of fish sent for diagnosis (July 2017,
n = 6), all specimens displayed varying degrees of central nervous system (CNS) signs with erratic swimming, buoyancy and equilibrium problems, or complete lethargy (
Supplementary Material, Video S1). Most fish hyperventilated, and all fish had below-average body condition (
Figure 1a). At necropsy, eyes were clear and there was no sign of exophthalmia or presence of gas bubbles in the skin or mouth. No external parasites were identified via direct microscopy of skin and gill scrapings. Gills were pale and abdomens were distended. One fish had petechial hemorrhages in the skin at the pelvic fins and the anus (
Figure 1b). The abdominal distension was caused by air-filled ventricles (
Figure 1c). Little or no feed residues were present in the gastrointestinal system. Swim bladders were completely deflated in all fish (
Figure 1d). The intestine was hyperemic in two fish (
Figure 1d). Spleens could not be identified. Kidneys were thin and pale.
The second batch of fish (August 2017, n = 10) was sent in two different boxes marked as “healthy” (n = 5) and “diseased” (n = 5). The farmer selected and separated the fish into these two groups for transport based on their behavior in the fish tank. The five “diseased” and one of the “healthy” juveniles displayed the same CNS signs as described above and the fish were thin. Gills were slightly to moderately pale. In a few fish, pupils were dilated, and the skin was darker than normal. Hematocrit was measured and appeared lower in the diseased group (21–30%, n = 3) compared to the “healthy” group, (29%, n = 1; 45–53%, n = 4), but determined as non-significant using Fisher’s exact test. For two juveniles in the diseased group, hemolysis made interpretation of hematocrit impossible.
2.3. Histology and Cytology
Severe epithelial hypertrophy and mild lymphocytic infiltration was seen in the gill epithelium; however, typical iridoviral inclusions were not seen (
Figure 2a). Necrotic lesions or presence of vacuoles indicative of viral nervous necrosis (VNN) could not be seen in the brain. One potential iridovirus inclusion was seen in the lip of one fish (
Figure 2b). Gas bubbles could not be detected in any of the investigated tissues. Blood smears showed regenerative anemia, with a high number of degenerated erythrocytes, erythroblasts, and proerythrocytes (
Figure 3). Anemia and regeneration were more prominent in July than in August.
2.4. Virology and Bacteriology
All samples used to inoculate cell cultures produced negative results despite the multiplicity of cell lines and temperatures tested (
Table 1). Two subsamples (sample 1-1, 1-2) of internal organ pools (including brain) from three fish in July were negative for NNV but gave faint signals for AcIV-E in quantitative real-time polymerase chain reaction (qRT-PCR). From one of the samples, an amplicon could be obtained using conventional PCR. The amplicon was sequenced, confirming presence of AcIV-E (
Table 2, sample 1-1). Subsequent qRT-PCR of gill tissue, considered to be the target tissue for AcIV-E detection [
2], collected in August provided further evidence for the presence of AcIV-E DNA (
Table 2, samples 2-1–2-5, 2-7, 2-9). Conventional PCR confirmed the qRT-PCR results and a partial sequence of the major capsid protein (
MCP) gene (1303 bp) was obtained. Sequence analysis revealed a nucleotide similarity of 99% with previously published sequences of AcIV-E. The new sequence was submitted to GenBank under the accession number MH817858.
No bacterial growth except for sparse mixed flora in the ventricle of one fish was detected.
3. Discussion
The only pathogenic agent found in the diseased sturgeon was AcIV-E. AcIV-E was described in both Siberian and Russian sturgeon [
1,
3]. In an Italian farm rearing both species, higher mortality due to AcIV-E was present in Russian sturgeon compared to Siberian sturgeon—90% vs. 50% [
1]—suggesting a lower susceptibility to the virus in Siberian sturgeon [
1,
3]. In the case described here, a cumulative mortality of 95% (including the initial 30% mortality around transport) was reached two months from arrival in the imported batch of juvenile Siberian sturgeon.
Despite inoculation on several cell lines, no virus growth was seen. So far, only white sturgeon iridovirus was successfully isolated upon cell culture [
6], whereas AcIV-E is yet to be isolated [
3]. Thus, our negative cell culture results did not exclude iridovirus infection, but rather, helped exclude other viruses such as NNV and infectious pancreatic necrosis virus (IPNV), which multiply on some of the cell lines used.
Sturgeon iridoviruses infect epithelial cells in gills, oropharynx, nasal organs, and the epidermis [
7], and are known to cause a chronic wasting syndrome [
6]. However, infection was also associated with neurological signs [
1,
2]. The farmer’s suspicion of gas bubble disease was not considered a probable diagnosis after observation of live juveniles and necropsy, since the neurological signs and necropsy findings together strongly indicated the presence of a viral infection based on previous observations [
1,
2,
6]. Clinical signs agreed with what was described for AcIV-E in Russian sturgeon [
2]; however, infection with NNV was also a possibility. Histopathology was not indicative of NNV infection. Gill epithelial hypertrophy could indicate iridoviral infection; however, only one potential iridoviral inclusion body was found in the lip epithelium. This specific fish was not tested by PCR, and thus, infection was not confirmed. However, molecular biology analyses confirmed the presence of AcIV-E and absence of NNV in samples from other fish. Low prevalence of typical iridoviral histological lesions in AcIV-E-infected Siberian sturgeon was previously described [
3]; thus, the histopathology in this case is in line with previous findings.
Regenerative anemia can be an effect of viral infection. Consistent with the epitheliotropic nature of sturgeon iridoviruses, it should not be present, and it was not described in any of the available references regarding AcIV-E. However, anemia is common in infections with systemic iridoviruses such as red sea bream iridovirus (RSIV) and infectious spleen and kidney necrosis virus (ISKNV) [
8] in fish. Further investigations of new cases are needed to determine if this is a clinical sign caused by AcIV-E. The observed hyperventilation was probably due to both the anemia and the infection/hypertrophy of the gill epithelium, as both cause a decreased ability to extract oxygen from the water, which induces hypoxia. Why the fish swallowed so much air that their ventricles were distended is unclear. Air-filled ventricles and intestines were also observed in other AcIV-E outbreaks (A. Toffan, personal communication).
There were no indications of concurrent bacterial disease affecting the fish; however, poor transport conditions probably contributed to the high mortality by inducing severe stress, predisposing infected individuals to developing disease, and increasing infection susceptibility in uninfected individuals [
9], thus triggering the onset of clinical disease from a latent infection.
Infectious disease is a major bottleneck for the development of aquaculture activities, and viral diseases in particular represent a challenge due to the lack of treatment. Disease control in sturgeon farming is difficult because of the lack of knowledge about disease epidemiology and control methods [
1]. Thus, there is poor implementation of preventive and control measures for viral diseases of sturgeon. Further problems arise because none of the sturgeon viruses are controlled through legislation. EU member state (MS) authorities only take EU-regulated diseases and those diseases that the MS accept have additional guarantees taken into account upon import. For Sweden, which is classified as free from all EU-listed fish diseases and has no other serious viral diseases that are detected regularly, this poses a major threat to fish health. This case is one example of what can happen when potentially serious infections are overlooked when fish are transferred from one farm to another, whether crossing a border or not. For aquaculture in general, not only for Sweden, an overview of diseases, and in particular the viral ones, in other species than salmonid fish is necessary. For example, the provision of species- or fish-group-specific recommendations for health certificates at the time of sale both regionally and internationally could be suggested to prevent the spread of diseases with large economic losses for the purchasing farms, as well to prevent introduction of serious disease to new regions. This would also provide a knowledge base and leverage for MS authorities to apply for additional guarantees regarding specific diseases threatening important aquaculture species in their countries.
4. Materials and Methods
Juveniles were sent live in two batches to the Swedish National Veterinary Institute (SVA) for necropsy and further analysis. The first batch, sent in July, contained six diseased juveniles. The second batch, sent in August, contained ten fish, of which five were considered as healthy by the farmer. Euthanization was performed using an overdose of buffered tricaine (MS-222). Five milliliters of 25 mg/mL MS-222 solution and 4.5 mL of 20 mg/L NaHCO3 buffer were added to a bucket containing 1 L of water and sturgeon juveniles. For the second batch, two buckets were used to keep the two groups separate. Fish were immediately necropsied, and tissues were sampled from fish with apparent clinical signs, and, from the second batch, also from two fish without symptoms (of which samples from one fish were used) for various analyses as described below.
Hematocrit was measured in the second batch of fish. Blood smears were made by cutting the tail and one drop of blood was put on a glass slide and spread out using another slide. Dried blood smears were stained with May Grünewald Giemsa using a modified protocol from Pappenheim [
10]. Selected tissues (brain, kidney, liver, gills, spleen, and ventricle) and two whole juveniles were preserved for histology in 4% buffered formaldehyde for five days. Tissues were then embedded in paraffin and prepared for microscopy using standard procedures. Sections were stained with hematoxylin and eosin (H&E). Sections were visualized at 2–100× using light microscopy.
Fish other than salmonids are still rare in Swedish aquaculture, and viral diagnostics for non-salmonid viruses, except spring viremia of carp (SVC) and koi herpesvirus (KHV), are not present at the SVA. From the first batch, internal organs (kidney, heart, spleen, and brain) from three fish were, thus, put in Eagle’s minimum essential medium (EMEM), prepared for cell culture inoculation, frozen at −70 °C as two subsamples, and sent on dry ice to the EU reference laboratory for fish in Kongens Lyngby, Denmark for viral cultivation and to Istituto Zooprofilattico Sperimentale delle Venezie (IZSVe), Italy for PCR and subsequent sequencing. From the second batch of fish, individual organs (kidney, heart, spleen, brain, and gills) were also put in PCR tubes and frozen at −70 °C. Individual gill samples from all five diseased (samples 2-1–2-5) and two “healthy” (samples 2-7, 2-9) (of which one had clinical signs of disease) were sent on dry ice to IZSVe for PCR and subsequent sequencing. Fish 6 (sample 2-6), 8 (sample 2-8) and 10 (sample 2-10) from the last batch were not used for PCR analysis. Viral cultivation was performed on pooled samples of spleen, kidney, heart, and brain. Samples were ground with sterile sand quartz in sterile cooled mortars, diluted 1:10 in EMEM supplemented with 10% fetal bovine serum, 2% antibiotic/antimycotic solution containing 10.000 IU/mL penicillin G, 10 mg/mL streptomycin sulfate, 25 μg/mL amphotericin B, 0.4% 50 mg/mL kanamycin solution, and centrifuged at 4000×
g at 4 °C for 15 min. Supernatants were collected and kept at 4 °C overnight to give the antibiotics time to inhibit bacterial growth. Thereafter, supernatants were inoculated at final dilutions of 1:100 and 1:1000 onto several cell lines and incubated at different temperatures (see
Table 1,
Section 2.4 for details). Cultivation was done for seven days, followed by a passage to fresh cells and sub cultivation for another seven days before final observation for cytopathological effects.
RNA was extracted using NucleoSpin
® RNA (Macherey-Nagel) according to the manufacturer’s instruction. The qRT-PCR for nervous necrosis virus (NNV) was performed according to the protocol developed by Baud et al. [
11].
DNA was extracted using the High Pure PCR Template Preparation Kit (Roche, Mannheim, Germany) according to the manufacturer’s instruction, and qRT-PCR for AcIV-E was performed as previously described [
3]. Briefly, targeting the AcIV-E major capsid protein (
MCP) gene, the qRT-PCR reaction was performed in 25 µL with 400 nM of each primer (oPVP346 and oPVP347) and a 150-nM probe tqPVP20 (Multiplex PCR kit; Qiagen, Hilden, Germany). Reactions were performed on a CFX 96 apparatus (Bio-Rad, Hercules, CA, USA). The following protocol was adopted: initial denaturation for 15 min at 95 °C, 40 cycles of denaturation for 15 s at 94 °C and annealing for 60 s at 60 °C. A positive control (plasmid kindly provided by Dr. Laurent Bigarré, ANSES, France), as well as negative controls, was used in each run.
Confirmatory conventional PCR was performed on samples positive in qRT-PCR. Primers oPVP339–oPVP344 targeting a large segment of the MCP gene was used. Briefly, PCR was performed in 25 µL with 800 nM of each primer, 1.5 mM MgCl2, 200 µM deoxyribonucleotide triphosphate (dNTP), and 1.25 U Platinum Taq (Platinum Taq DNA polymerase kit; Invitrogen, Carlsbad, CA, USA). The following cycles were applied: one step of 5 min at 95 °C for Taq polymerase activation, followed by 40 cycles at 94 °C for 30 s, 53 °C for 30 s, 72 °C for 60 s, and a final extension at 72 °C for 10 min. A volume of 7 µL of end product was run on 7% acrylamide gel at 200 V, 400 mA, 100 W for 40 min.
Sanger sequencing was done according to standard procedures [
12]. Sequencing data were assembled using SeqScape v2.5 (Applied Biosystems, Foster City, CA, USA).
Sampling for bacteriology was done from kidney and ventricle in two fish from the first batch. Samples were inoculated on 5% horse blood agar and Tryptone Yeast Extract Salts (TYES) agar and incubated at 20 °C for five days.